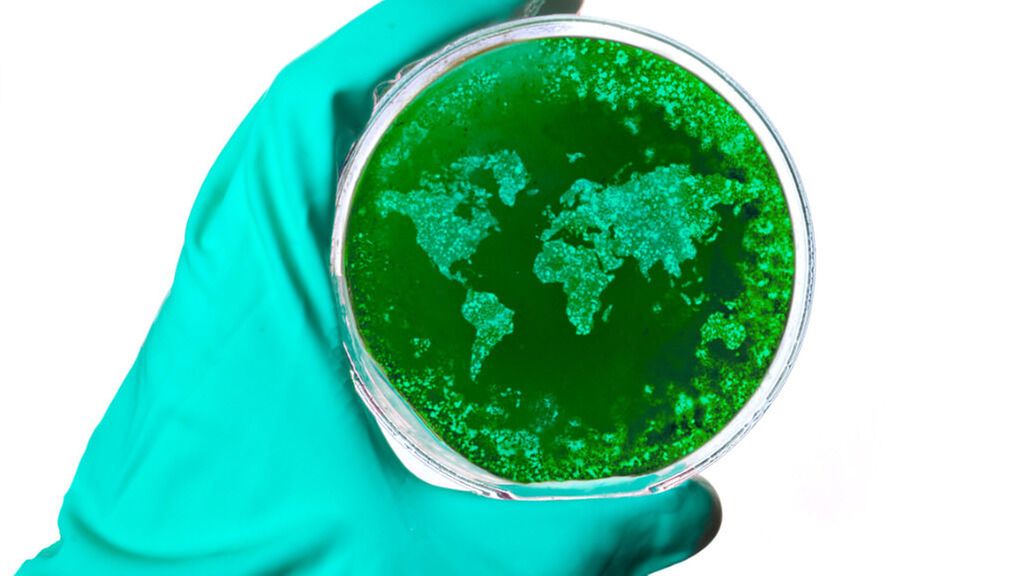

Autoinflammation: periodische Fiebersyndrome
Jatros
30
Min. Lesezeit
20.12.2018
Weiterempfehlen
<p class="article-intro">Die meist zuerst im Kindesalter auftretenden periodischen Fiebersyndrome sind ätiologisch geklärt: Es handelt sich um monogenetische Veränderungen, die das angeborene Immunsystem betreffen. Man spricht von „Autoinflammation“, die nicht mit Autoimmunität verwechselt werden darf.</p>
<p class="article-content"><div id="keypoints"> <h2>Keypoints</h2> <ul> <li>Periodische Fiebersyndrome beruhen auf dem Prinzip der Autoinflammation, einer genetisch bedingten Fehlregulation des angeborenen Immunsystems.</li> <li>Da Interleukin 1 bei der Autoinflammation eine zentrale Rolle spielt, können IL-1-Rezeptorantagonisten als Therapie periodischer Fiebersyndrome eingesetzt werden.</li> </ul> </div> <p>Fieber kann ein Zeichen für eine Infektion sein. Daneben gibt es aber eine Vielzahl anderer Fieberursachen, zum Beispiel die periodischen Fiebersyndrome; aber auch chronisch-entzündliche Erkrankungen oder Neoplasien können Fieber verursachen. Für den klinischen Infektiologen sind diese Fieberursachen differenzialdiagnostisch von Bedeutung.<br /> Zunächst liegt meistens ein Fieber unklarer Genese („fever of unknown origin“ – FUO) vor. Dieses ist definiert durch Bestehen seit mindestens drei Wochen. In dieser Zeit müssen mehrfach Temperaturen über 38,3°C aufgetreten sein und es darf – trotz intensiver Untersuchung – keine Diagnose vorliegen.</p> <h2>Pathogenese: Autoinflammation vs. Autoimmunität</h2> <p>Das angeborene Immunsystem hat die Fähigkeit, auf bestimmte Gefahrensignale zu reagieren. Diese Stimulation führt zur Aktivierung des Inflammasoms. Dieser Proteinkomplex verstärkt die Synthese und Sekretion unter anderem der Interleukine 1 und 18. <br />Bestimmte genetische Veränderungen, etwa im NLRP3-Gen, können nun dazu führen, dass der Inflammasom-Komplex auch ohne entsprechende Stimulation aktiviert bleibt – man spricht hier von „Autoinflammation“. Dieser pathophysiologische Prozess muss von der Autoimmunität unterschieden werden. Bei Autoimmunprozessen sind spezifische Antikörper gegen körpereigene Strukturen und autoreaktive T-Lymphozyten vorhanden – es handelt sich also um eine Fehlaktivierung des adaptiven Immunsystems. Bei durch Autoinflammation charakterisierten Erkrankungen, zu denen auch die periodischen Fiebersyndrome zählen, fehlen spezifische Antikörper und autoreaktive T-Zellen. <br />Allerdings gibt es eine ganze Reihe weiterer Erkrankungen, bei denen Autoinflammation (zum Teil auch gleichzeitig mit Autoimmunität) eine Rolle spielt. Autoinflammation findet sich beispielsweise bei multifaktoriellen entzündlichen Erkrankungen (nicht bakterielle Osteomyelitis), aber auch bei Unterformen von klassischen Autoimmunerkrankungen (zum Beispiel systemischer Lupus erythematodes) und kardiovaskulären Erkrankungen. Von manchen Autoren wurde als Modell ein Kontinuum immunologischer Erkrankungen vorgeschlagen, wobei die in erster Linie autoinflammatorisch bedingten Erkrankungen am einen, die primär autoimmun bedingten Störungen am anderen Ende lokalisiert wären. Dazwischen würden Krankheiten liegen, bei denen beide pathophysiologischen Vorgänge eine Rolle spielen (Abb. 1).</p> <p><img src="/custom/img/files/files_datafiles_data_Zeitungen_2018_Jatros_Infekt_1804_Weblinks_s9_abb1.jpg" alt="" width="1417" height="936" /></p> <h2>Periodische Fiebersyndrome</h2> <p>Der Begriff der Autoinflammation wurde Ende des 20. Jahrhunderts anhand einer Gruppe von monogenetisch bedingten, Zytokin-getriebenen Erkrankungen – eben der periodischen Fiebersyndrome – definiert. Die wichtigsten davon werden hier ganz kurz erwähnt. <br /><br /><strong>Familiäres Mittelmeerfieber</strong> <br />Das familiäre Mittelmeerfieber (FMF) entsteht durch eine rezessiv vererbte Mutation im MEFV-Gen, das Pyrin kodiert. Pyrin ist ein negativer Regulator des NLRP3-Inflammasoms. Das FMF ist charakterisiert durch relativ kurze, meist ein bis drei Tage dauernde Fieberepisoden, die mit Serositis (abdominelle sowie pleuritische Schmerzen), Arthritis und erysipeloidem Exanthem einhergehen. <br /><br /><strong>TRAPS</strong> <br />Autosomal-dominante Veränderungen in jenem Gen, das den TNF-alpha-Rezeptor kodiert (TNFRSF1A), führen zum sogenannten TNF-Rezeptor-assoziierten periodischen Syndrom (TRAPS). <br />TRAPS manifestiert sich als dramatische, meist etwa eine Woche dauernde Episoden von Fieber, Serositis, Periostitis, Myalgie und Arthritis. Ein passageres Exanthem, Photophobie, Konjunktivitis und periorbitale Ödeme kommen ebenfalls vor.<br /><br /><strong>CAPS</strong> <br />Die Cryopyrin-assoziierten periodischen Syndrome (CAPS) werden durch Mutationen im NLRP3-Gen verursacht. Diese führen dazu, dass sich das Inflammasom spontan bildet und deshalb das proinflammatorische IL-1-beta vermehrt sezerniert wird. <br />CAPS bilden ein Spektrum von Erkrankungen, das vom eher milden „familial cold autoinflammatory syndrome“ (FCAS) bis zu schwereren Manifestationen wie dem Muckle-Wells-Syndrom (MWS; Taubheit und Amyloidose) und der schwersten Manifestation, der „neonatalonset multisystem inflammatory disease“ (NOMID bzw. CINCA; Letzteres steht für „chronic infantile neurological cutaneous and articular syndrome“; ZNS-Komplikationen, Papillenödem, aseptische Meningitis, Fieber, Retardierung, muskuloskelettale Symptome, vorzeitige Verknöcherung etc.), reicht. <br />Daneben existieren weitere, auf verschiedenen Mutationen beruhende, autoinflammatorische Erkrankungen.</p> <h2>Therapiemöglichkeiten</h2> <p>Da Interleukin 1 im Zentrum der pathologischen Vorgänge bei periodischen Fiebersyndromen steht, sind IL-1-Antagonisten eine sinnvolle Therapieoption. Hier ist an erster Stelle der IL-1-Rezeptorantagonist Canakinumab zu nennen, der als Therapie bei FMF, TRAPS, CAPS und anderen periodischen Fiebersyndromen zugelassen ist. Bei CAPS kann auch der IL-1-Rezeptorantagonist Anakinra (ab einem Lebensalter von acht Monaten) verwendet werden.</p></p>
<p class="article-quelle">Quelle: „Periodische Fiebersyndrome“, Vortrag von Priv.-Doz.
Mag. Dr. med. univ. Jürgen Brunner, Universitätsklinik für
Pädiatrie I, MedUni Innsbruck, 26. Jahrestagung der Paul-
Ehrlich-Gesellschaft (PEG), 5. Oktober 2018, Wien, Symposium
unterstützt von Novartis
</p>
<p class="article-footer">
<a class="literatur" data-toggle="collapse" href="#collapseLiteratur" aria-expanded="false" aria-controls="collapseLiteratur" >Literatur</a>
<div class="collapse" id="collapseLiteratur">
<p>beim Vortragenden</p>
</div>
</p>
Das könnte Sie auch interessieren:
Zytomegalievirus: an die Risiken der Reaktivierung denken!
Infektionen mit dem Zytomegalievirus (CMV) verlaufen bei Gesunden zumeist asymptomatisch, führen jedoch zur Persistenz des Virus im Organismus. Problematisch kann CMV werden, wenn es ...
Medikamenteninteraktionen: hochrelevant im klinischen Alltag
Bei gleichzeitiger Einnahme mehrerer Medikamente ist die Wahrscheinlichkeit hoch, dass diese einander beeinflussen. Diese Wechselwirkungen können zum kompletten Wirkungsverlust oder auch ...
Update EACS-Guidelines
Im schottischen Glasgow fand im November 2024 bereits zum 31. Mal die Conference on HIV Drug Therapy, kurz HIV Glasgow, statt. Eines der Highlights der Konferenz war die Vorstellung der ...